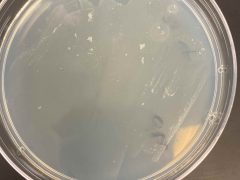

Description
The soil sample in this experiment was obtained from a location near a Bayou in Richmond area, 77407, Tx. I dug a 6-inch hole near water area, collecting the sample in an amber tube to shield it from sunlight
Data for Soil Sample and Researcher
Location of Soil Sample
7530 Rainham Valley Ln, Richmond, TX 77407, USA, 7530 Rainham Valley Ln, Richmond, Texas 77407, Nigeria, 29.677343, -95.719452
Collection Date of Soil Sample
Paraoxon Count May Not Be Exact
Yes
Methyl Parathion May Not Be Exact
Yes
Researcher
Anike Eyimogbo
Organization
University of Houston
Lab Day
Monday
Time of Lab
4:00 PM
Course Term
Summer
Year of Course
2024
Image Descriptions in General
Week 1: exhibited promising results due to yellow/brown colr formation across the cultubes
Wee2-5: Showed little to no growth due to lack of colortion or cloudiness observed.
Px/Mp : Overgrowth. will be retested
Extended Analysis Results
Cataloged
No